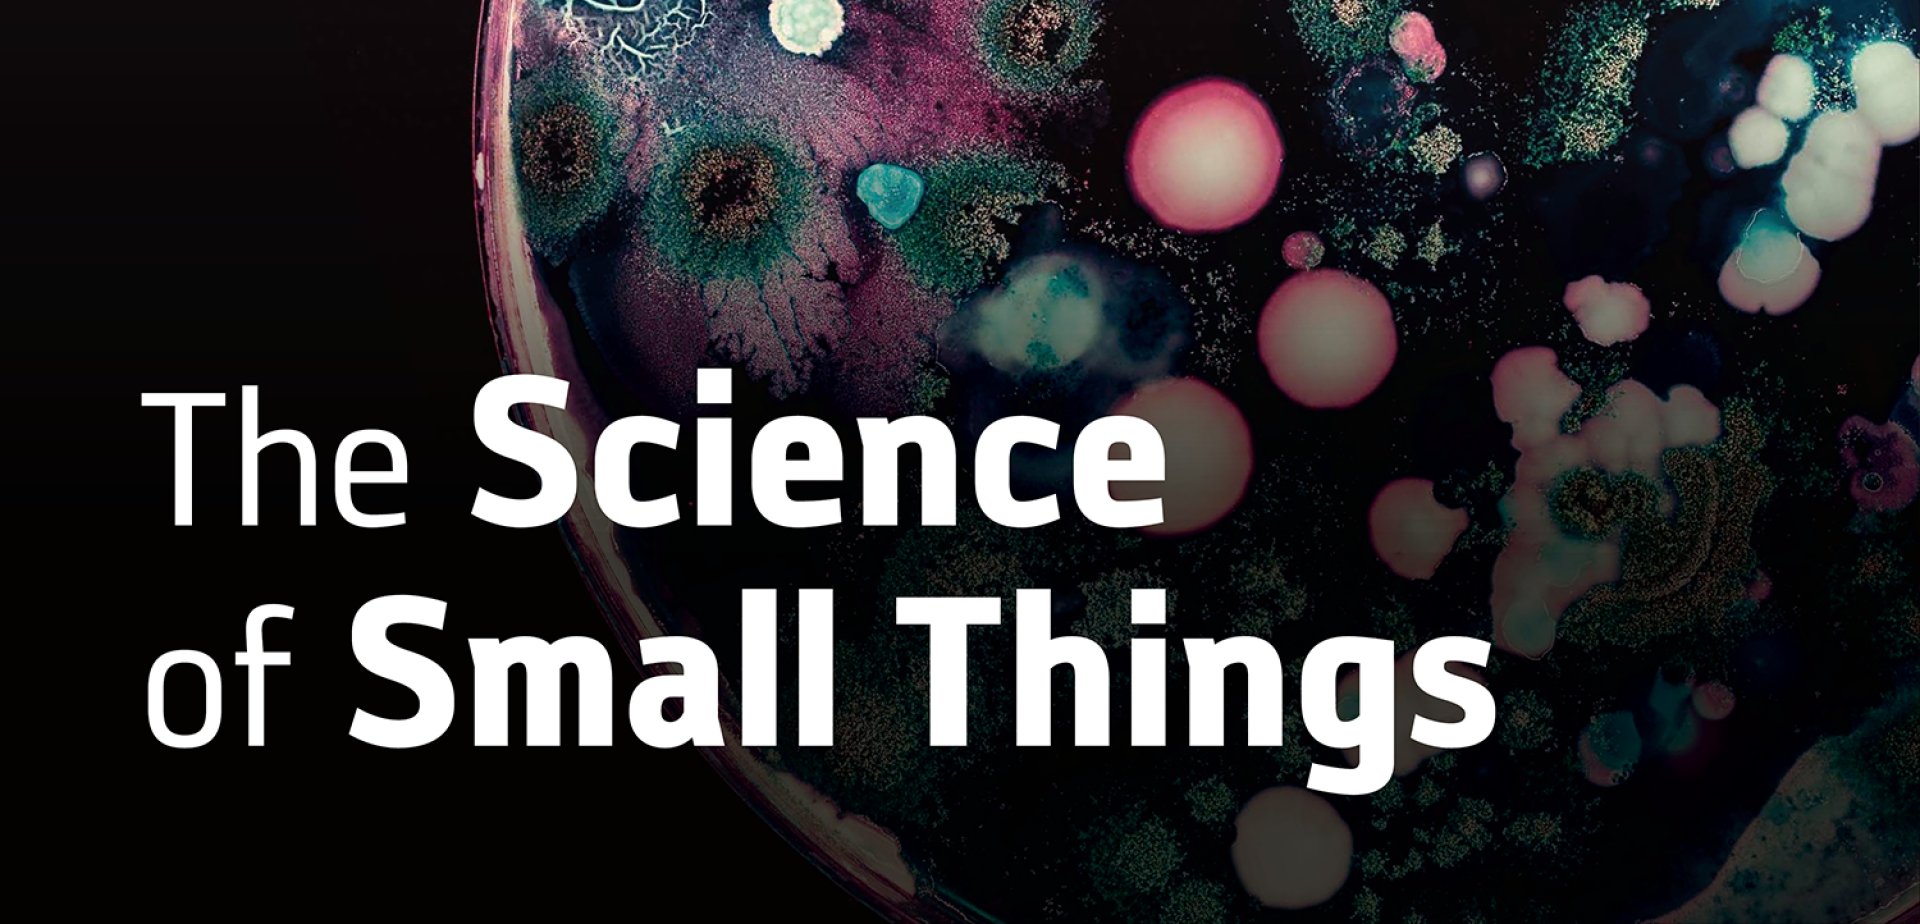

This page features a list of upcoming rallies and grassroots resources curated by KRCL's RadioACTive team.
♦♦♦♦♦♦♦♦♦♦♦♦♦♦♦♦♦♦♦♦♦♦♦♦♦♦♦♦♦♦♦♦♦♦♦♦♦♦♦♦♦♦♦♦♦♦♦♦♦♦♦♦♦♦♦♦♦♦♦♦♦♦♦♦♦♦♦♦♦♦♦♦♦♦♦♦♦♦♦♦♦♦♦♦♦♦♦♦♦♦♦♦♦♦♦♦♦♦♦♦♦♦♦♦♦
Community Resources, Training and Safety Links:
Call Your Representative About ICE:
♦♦♦♦♦♦♦♦♦♦♦♦♦♦♦♦♦♦♦♦♦♦♦♦♦♦♦♦♦♦♦♦♦♦♦♦♦♦♦♦♦♦♦♦♦♦♦♦♦♦♦♦♦♦♦♦♦♦♦♦♦♦♦♦♦♦♦♦♦♦♦♦♦♦♦♦♦♦♦♦♦♦♦♦♦♦♦♦♦♦♦♦♦♦♦♦♦♦♦♦♦♦♦♦♦
March is Women's History Month:
Driving the Vote for Equality starts March 1, 2026. "More than 100 years ago, two women undertook an epic road trip in support of women’s suffrage. In 2026, ERA NOW and other supporting groups are determined to follow in their tracks in support of full constitutional equality. During March 2026, Women's History Month, ERA NOW will kick off a 10,500-mile tour called Driving the Vote for Equality. We will travel from the east to the west coasts, starting and ending in New York City." To sign the ERA petition, visit sign4era.org.
Wednesday, March 4:
Hill Talk Community Action Fair | 6:00-7:30 PM @ Church & State, 370 S 300 E, SLC. Event by Elevate Utah, Better Boundaries & Better Utah: "Feeling angry, sad, or scared about the state of the world? Pause the doomscrolling and come meet organizations from across the county & state who are doing amazing work to make our community a better place. Come enjoy free pizza, drinks, and community!"
Faculty Book Talk | The Future of Press Freedom: Democracy, Law, and the News in Changing Times | 12:00-1:30 PM on Zoom. Event by S.J. Quinney College of Law - University of Utah: "Professor RonNell Andersen Jones will discuss her new book The Future of Press Freedom: Democracy, Law, and the News in Changing Times. She will be joined by co-editor Professor Sonja R. West and book contributors Professor Helen Norton, Associate Professor Christina Koningisor, and Professor Victor Pickard. Andersen Jones' book assembles media experts and First Amendment luminaries to chart the future of press freedom in America's changing media landscape. Current and former deans of top U.S. law schools, a Pulitzer Prize-winning journalist, former Supreme Court clerks, and renowned scholars of law and communications offer their collective wisdom on safeguarding journalism amidst unprecedented challenges." FREE to attend or $15 for CLE Credit. For details, click here.

Thursday, March 5:
Utah's Statewide Virtual Job Fair| 10A-1P online. Event by Utah Department of Workforce Services: "Open to all job seekers with priority to veterans, military members and spouses. Get hired online! To register as a job seeker, please visit jobs.utah.gov and create an account or sign in to "My Job Search" (indicate your military or spouse status). Locate the Virtual Job Fair or Prep Workshops on your Dashboard. From there, select the event(s) to proceed. Job fair prep workshop available the day before from 10A-1P." For helpful videos to prepare for the fair and a list of employers expected to join the fair, click here.
Clean Slate Utah Expungement Clinic with SJ Quinney Pro Bono Initiative | 5:00-6:30 PM @ USARA,180 E 2100 S #203, SLC. "Want your record expunged? Free in-person expungement consultations on the first Thursday of every month. No registration required. Walk-ins welcome." For more info, call 801-7581-5418 or email probono@law.utah.edu.
Book Talk: The Glorians | 7 PM at the SLC Public Library, 210 E 400 S, SLC. Terry Tempest Williams in conversation with Ken Sanders about her new book, The Glorians: Visitations from the Holy Ordinary. “Terry Tempest Williams will be sitting down for a heart-to-heart with her old friend, Ken Sanders. Ken and Terry have known each other since they worked together at Sam Weller’s in the 1970s. This will be a conversation you will not wish to miss. The ticket to the event includes a signed first edition copy of The Glorians to be picked up at the event and access to the after-party at Ken Sanders Rare Books, where music and refreshments will be provided. It is important to note that Terry will not be signing anything at the event. Signed copies of The Glorians are available here for those who cannot attend.”
FRI-SAT, March 6-7:
Illuminate 2026 | 5-10 PM @ Library Square, SLC. Event by Illuminate - Utah's Light Art + Creative Tech Fest: "ILLUMINATE is a festival celebrating the intersection between art and technology. Utah Arts Alliance works with a wide variety of artists, makers, performers, and community partners to showcase innovative creativity through large-scale art pieces, an interactive STEAM Lab, drone shows, and multimedia artwork." Presented by the Utah Arts Alliance.
FRI-SUN, March 6-8:
GPC International Grower's Convention in SLC. Early bird registration ends Jan. 31. To register, click here. "Registration is now open for the 2026 International Growers Convention in Salt Lake City, Utah! Join us from Friday, March 6th, through Sunday, March 8th, for an unforgettable weekend of learning, networking, and celebration." A late registration fee will apply after February 1.

Saturday, March 7:
Lucky Clover Market - Creators for a Cause | 10A-2P @ Switchpoint Coffee Co., 2080 W North Temple St, SLC. Featuring 20+ local vendors, coffee and food from @switchpointcoffee.slc, and good vibes all around. A benefit for Switchpoint CRC and its work to end homelessness.
Women In Music: Utah Chapter Launch Party | 3-10 PM @ Asher Adama & The Depot, 13 N 400 W, SLC. "Join us for inspiring panel discussions with 6 women in the industry! 3 PM | ALL AGES. Free Coffee. Join us after the panel discussions at The Depot for LIVE performances by Eternal Loser, Detzany and Anna Beck @ 5:30 PM. All ages. For $10 tickets for the show, click here.
Monday, March 9:
Volunteer with Burrito Project SLC and Spread Love, One Burrito at a Time | 5 PM on various dates throughout March @ Fierro HPP & Distribution, 940 W 100 S, SLC. "The Burrito Project is back! Join us on Mondays and Wednesdays to support individuals in vulnerable situations by preparing and sharing fresh, homemade burritos."
Monday, Mar 9
Monday, Mar 16 & Wednesday, Mar 18
Monday, Mar 23 & Wednesday, Mar 25
Monday, Mar 30.
Sign up to volunteer: tinyurl.com/SlcBurritos. Bring your energy, your smile, and your heart!
Public Town Hall for the 8 Democratic candidates for Congress in Utah’s CD-01 | 6:30-8:45 PM @ Salt Lake City Public Library Downtown, 210 E 400 S, SLC, in the Tessman Auditorium. Event by the 71 Percent Coalition and Black Lives Matter Utah Chapter. To RSVP and pose a question for candidates in advance, click here.
Friday, March 13:
RadioACTive's Punk Rock Farmer Friday Live Broadcast | 6-7 PM @ 801 Coffee Roasters, 550 N 300 W, SLC. Join Aldine and the RadioACTive Team for a special Radiothon Eve broadcast in the community. We'll have more true tales of the agrihood and homegrown music from Murphy & The Giant! FREE and open to the public. Plus, we just may have new Punk Rock Farmer T-shirts available before anyone else can get their hands on one!

FRI-SAT, March 13–14:
Tuesday, March 17: Happy St. Patrick's Day or Merry Caucus Night. Just remember the order of celebrations!
Wednesday, March 18:
Pints & Policy: A Legislative Recap with HEAL Utah | 6-8 PM @ Fisher Brewing, 320 W 800 S, SLC. "Join us for our 2026 Legislative Recap as we cool down from an intensive legislative session. Whether you are an experienced HEAL community lobbyist or a total newcomer, all are welcome. We’ll be covering bills we tracked throughout the session, highlighting advocacy impacts, and providing a Q&A with our policy experts so that you can learn more. Sip on your favorite beer or kombucha as we break down the legislative process and spill the tea on upcoming environmental policies." 21+, valid ID required. To RSVP, click here.
Thursday, March 19:
Utah Organic Farming Summit: Shaping an Organic Future, Together | 8:30a-5:00p @ Clubhouse on South Temple, 850 E South Temple St., SLC. Event by Utah Transition to Organic Partnership Program (UT-TOPP) and Red Acre Center: "Learn, connect, and help shape the future of organic agriculture in Utah. Whether you’re organic-curious, transition-ready, or already certified — and whether you farm a small market garden or manage hundreds of acres — this summit needs your voice at the table. Hear directly from successful organic farmers, state and regional organic experts, food system advocates, and organic certifiers. Dive into organic systems, fertility and weed management, seed use, certification pathways, USU organic research, available resources, and the real-world challenges and opportunities facing organic growers in Utah. Share a meal, build relationships, exchange ideas, and be part of what’s to come. Come learn. Come connect. Come help grow organic in Utah." For tickets, click here.

THURS-FRI, March 19-20:
Wallace Stegner Center Symposium: America's Public Lands | 8A-5P @ SJ Quinney College of Law, University of Utah, SLC. Virtual attendance is also offered. Event by S.J. Quinney College of Law - University of Utah: "Now in its 31st year, the symposium will focus on one of the most pressing issues of our time: the future of our public lands. Ryan Gellert (JD '05), CEO of Patagonia, will deliver the keynote address." For tickets and a full schedule, click here.

Friday, March 20:
Poster Art Pop Up: One Night Stand!- 7 PM at Copper Palate Press, 160 E 200 S, SLC. Featuring Furturtle and Lil Tuffy. Both artists will have a bunch of gig posters, art prints, stickers and other swag. Come on by, meet the artists and pick up a couple of their limited-edition, screen-printed posters!
Saturday, March 21:
9th Annual MWEG Spring Conference: With Liberty and Justice for All | 8A-4P @ Utah Valley University, Orem. "Throughout our history, women have always played a critical role in pushing America to live up to her highest values and promises. This is still true today. Come honor our nation's 250th anniversary and discover how we can courageously meet the challenges of the moment while also imagining a better future. Together we can fulfill our nation's promise." To register, click here. To apply for a scholarship, click here.

Saturday, March 28:
SAVE THE DATE: No Kings Rally SLC | 2:30 PM @ Washington Square Park (WSP), 451 S State St, SLC. March begins at 2:30 PM at WSP. Rally begins at 3:30 PM at the Utah State Capitol, 350 N State St, SLC.

Tuesday, April 14:
Unseen Impacts — Microplastics in Our Environment | 7:00 PM at NHMU, 301 Wakara Way, SLC. "Join us for an essential exploration of microplastics with a panel of three experts, including Sally Rocks, who will examine efforts to reduce microplastics in our oceans, investigate their impacts on the human body, and reveal where researchers are finding them here in Utah." This event is free to attend with registration.
Wednesday, April 15:
Sanctuary Film Screening, 7:00 PM at The Utah Film Center, 375 W, 400 N. This screening is part of the Utah Queer Film Festival. RSVP for free. “Sanctuary is a feature-length documentary that exposes the plight of LGBTQIA+ individuals within modern faith systems, told through the eyes of a visionary architect whose passion project becomes a lifeline. As doctrine collides with identity, a sacred space rises from rejection, offering refuge and hope. Alongside his journey, scholars and spiritual leaders from a variety of religious traditions share how they are transforming their institutions to welcome the marginalized and reimagine what it means to belong. Featuring a Q&A moderated by the Utah Queer Film Festival team with Co-Directors, Autumn McAlpin and Vienna Boyes and 'Sanctuary' architect Doug Staker.”
Tuesday, April 21:
Anand Varma: Inside Wonder Lab | 7 PM @ Kingsbury Hall, 1395 Presidents Circle, SLC. "The Natural History Museum of Utah 2026 Lecture Series Keynote Speaker is Anand Varma, a biologist, award-winning photographer, and National Geographic Explorer. He is the founder of WonderLab, a one-of-a-kind storytelling studio based in Berkeley, California. Varma has grown to fame for his efforts in advancing photography and videography techniques to better visualize often-unseen wonders of the world." For tickets, click here. ***Discount available for University of Utah students, faculty, and staff.
THU-SUN, Apr 30-May 2:
Topaz Pilgrimage 2026. "This pilgrimage will pay tribute to the 11,212 people of Japanese descent who were incarcerated at the Topaz WWII American concentration camp and allow participants to explore the legacy of Topaz as well as the Japanese American history in Salt Lake City and Utah. Our 2026 pilgrimage will be honored with a visit by the Ireicho: Book of Names on its national tour. Due to the overwhelming interest in the Ireicho, Topaz Pilgrimage participants cannot be guaranteed an appointment to personally stamp it. However, there will be an opportunity to convene as a group to honor the book at a ceremony on the Topaz site on Saturday, May 2. On the evening of April 30 and all day on May 1 in Salt Lake City, we will offer intergenerational programming, including activities at the Salt Lake Buddhist Temple and walking tours of historic Japantown and other local interests. On Saturday, May 2, bus transportation will take participants to and from Salt Lake City and Delta for a day trip to the Topaz Museum and the historic Topaz site. Registration ends March 31, or when registration reaches capacity. Click Here to REGISTER TODAY."
Saturday, June 6:
SAVE THE DATE: 49th Utah Asian Festival | 11A-10P @ Utah State Fair Park, 155 N 1000 W, SLC. Applications are NOW OPEN for booths, food vendors, and performances. Priority deadline: March 6, 2026. For more info, visit utahasianfestival.org.
###
Archived Saturday Sagebrush Serenade for Your At-Your-Convenience Listening Pleasue
READ MOREFrom blues to folk, electronica to world and everything in between, check out KRCL's DJs Best of 2019:
READ MOREFamous for being a member of the Nitty Gritty Dirt Band, and instrumentalist extrordinaire, John McEuen sat down with KRCL's John Florence for an indepth interview. McEuen is featured in the upcoming Ken Burns special on country music highlights the making of Will the Circle Be Unbroken, the landmark recording McEuen and the Nitty Gritty Dirt Band did in Nashville with the elder statesmen of country like Doc Watson, Merle Travis, Earl Scruggs, et al. in 1971.Listen In:
READ MOREJohn McEuen, founding member of the Nitty Gritty Dirt Band, stopped by KRCL for an indepth interview with A Brand New Day show host, John Florence. John McEuen and the String Wizards play The State Room on Thursday, January 31 with special guest Jonathan McEuen opening the show.
READ MORE